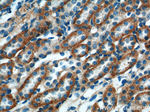
TXNIP Antibody in Immunohistochemistry (Paraffin) (IHC (P))
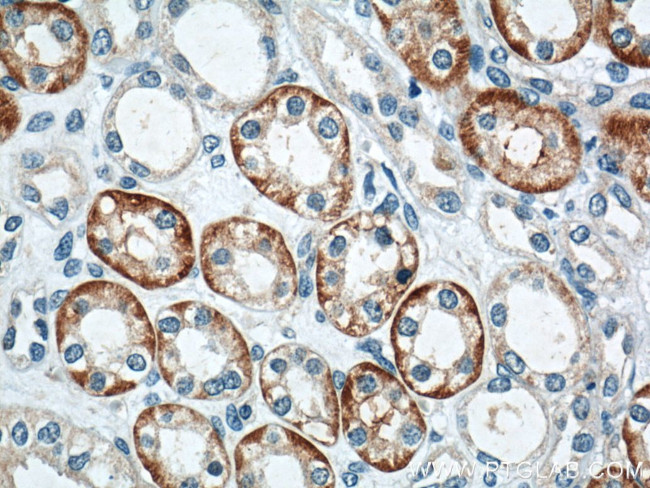
TXNIP Antibody in Immunohistochemistry (Paraffin) (IHC (P))

Search
Proteintech
TXNIP Polyclonal Antibody
{{$productOrderCtrl.translations['antibody.pdp.commerceCard.promotion.promotions']}}
{{$productOrderCtrl.translations['antibody.pdp.commerceCard.promotion.viewpromo']}}
{{$productOrderCtrl.translations['antibody.pdp.commerceCard.promotion.promocode']}}: {{promo.promoCode}} {{promo.promoTitle}} {{promo.promoDescription}}. {{$productOrderCtrl.translations['antibody.pdp.commerceCard.promotion.learnmore']}}

Please note: We are reviewing Western blot images included in the antibody testing data in our catalog, including those provided by third parties. Unless expressly labeled or annotated as “raw-unedited”, Western blot images included in the antibody testing data in our catalog may have been edited, optimized or otherwise adjusted for presentation.
产品信息
18243-1-AP
种属反应
已发表种属
宿主/亚型
分类
类型
抗原
偶联物
形式
浓度
规格
纯化类型
保存液
内含物
保存条件
运输条件
产品详细信息
Immunogen sequence: MVMFKKIKS FEVVFNDPEK VYGSGEKVAG RVIVEVCEVT RVKAVRILAC GVAKVLWMQG SQQCKQTSEY LRYEDTLLLE DQPTGENEMV IMRPGNKYEY KFGFELPQGP LGTSFKGKYG CVDYWVKAFL DRPSQPTQET KKNFEVVDLV DVNTPDLMAP VSAKKEKKVS CMFIPDGRVS VSARIDRKGF CEGDEISIHA DFENTCSRIV VPKAAIVARH TYLANGQTKV LTQKLSSVRG NHIISGTCAS WRGKSLRVQK IRPSILGCNI LRVEYSLLIY VSVPGSKKVI LDLPLVIGSR SGLSSRTSSM ASRTSSEMSW VDLNIPDTPE APPCYMDVIP EDHRLESPTT PLLDDMDGSQ DSPIFMYAPE FKFMPPPTYT EVDPCILNNN VQ (1-391 aa encoded by BC093702)
靶标信息
The members of the zinc fingers and homeoboxes gene family are nuclear homodimeric transcriptional repressors that interact with the A subunit of nuclear factor-Y (NF-YA) and contain two C2H2-type zinc fingers and five homeobox DNA-binding domains. This gene encodes member 2 of this gene family. In addition to forming homodimers, this protein heterodimerizes with member 1 of the zinc fingers and homeoboxes family.
仅用于科研。不用于诊断过程。未经明确授权不得转售。
生物信息学
蛋白别名: hyperlipidemia 1; thioredoxin binding protein-2; Thioredoxin-binding protein 2; Thioredoxin-interacting protein; upregulated by 1,25-dihydroxyvitamin D-3; Vitamin D3 up-regulated protein 1
基因别名: 1200008J08Rik; AA682105; Hyplip1; Tbp-2; THIF; TXNIP; VDUP1
UniProt ID: (Mouse) Q8BG60
Entrez Gene ID: (Mouse) 56338